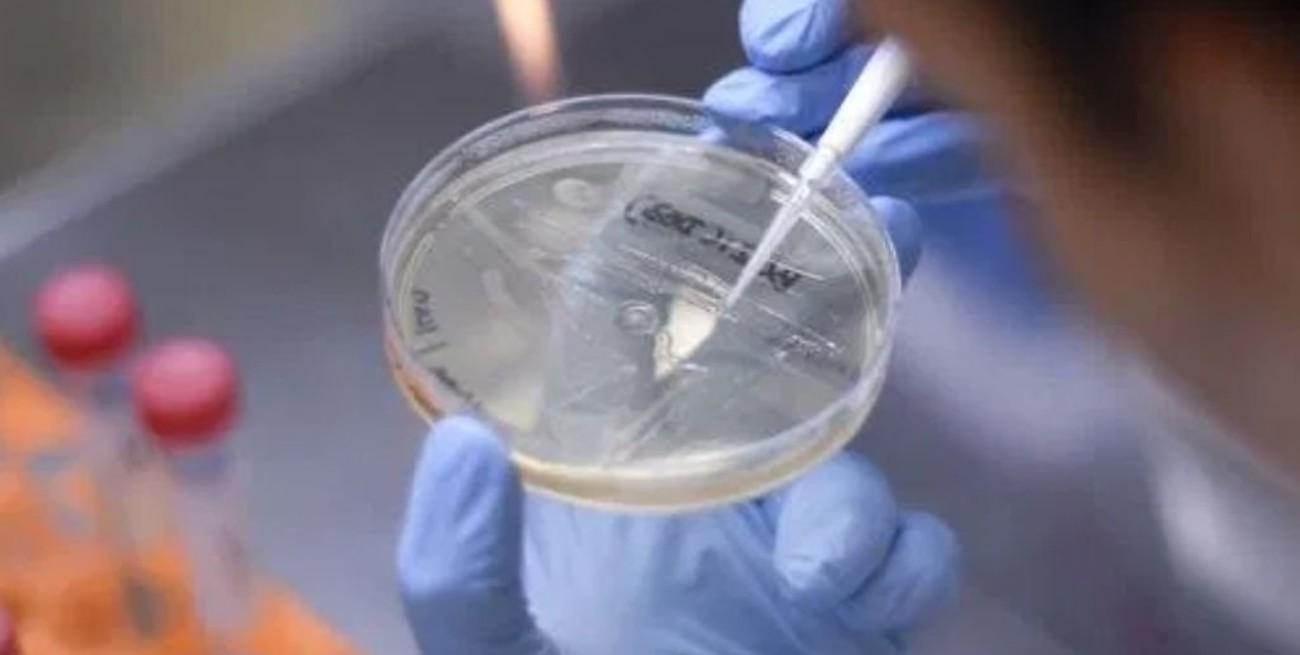

La variante Delta del coronavirus es 60% más contagiosa que su predecesora, la Alfa, afirma un estudio sanitario del Reino Unido.
Es la conclusión a la que llegaron las autoridades sanitarias británicas. Se detectaron 42.323 casos de la cepa en ese país.

La variante Delta del coronavirus es 60% más contagiosa que su predecesora, la Alfa, afirma un estudio sanitario del Reino Unido.
El ministro de Sanidad británico, Matt Hancock, había estimado recientemente este porcentaje en 40%.
Pero según un estudio de la Salud Pública de Inglaterra, se detectaron en el Reino Unido 42.323 casos, 29.892 más que hace una semana, de esta nueva cepa proveniente de la India que ya representa más del 90% de los nuevos contagios.

"La variante Delta se asocia con un riesgo aproximadamente 60% mayor de transmisión en el núcleo familiar" respecto a la variante Alfa, identificada en diciembre en el sureste de Inglaterra y causante de una disparada de casos que llevó a casi cuatro meses de confinamiento.
Sin embargo, el estudio considera "alentador" que este nuevo aumento no vaya acompañado de un incremento similar en las hospitalizaciones. Unos mil enfermos de covid-19 están actualmente ingresados en hospitales británicos.
"Los datos indican que el programa de vacunación sigue mitigando el impacto de esta variante" en las personas que ya recibieron dos dosis de la vacuna, señaló el organismo.
Aunque la vacunación "reduce el riesgo de enfermedad grave, no lo elimina", subrayó sin embargo Jenny Harries, directora general de la agencia de seguridad sanitaria británica.

El Reino Unido, país europeo más golpeado por la pandemia con casi 128.000 muertes, ha desplegado una campaña de vacunación masiva que en seis meses administró dos dosis al 77% de los adultos.
Tras un largo confinamiento invernal, el gobierno ha ido flexibilizando muy gradualmente las restricciones. Pero el levantamiento de las últimas medidas, previsto inicialmente para el 21 de junio, se ve amenazado por el reciente aumento de los contagios, que superan los 6.000 o incluso 7.000 nuevos casos diarios.
Según el diario The Times, el gobierno de Johnson está considerando posponer esa última etapa cuatro semanas, en una decisión que debe ser anunciada el lunes.